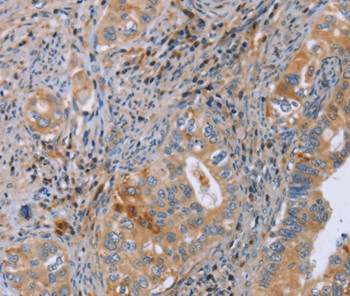
GMFG Antibody in Immunohistochemistry (Paraffin) (IHC (P))

Search
Invitrogen
GMFG Polyclonal Antibody
{{$productOrderCtrl.translations['antibody.pdp.commerceCard.promotion.promotions']}}
{{$productOrderCtrl.translations['antibody.pdp.commerceCard.promotion.viewpromo']}}
{{$productOrderCtrl.translations['antibody.pdp.commerceCard.promotion.promocode']}}: {{promo.promoCode}} {{promo.promoTitle}} {{promo.promoDescription}}. {{$productOrderCtrl.translations['antibody.pdp.commerceCard.promotion.learnmore']}}
产品信息
PA5-50345
宿主/亚型
分类
类型
抗原
偶联物
形式
浓度
规格
保存条件
运输条件
RRID
产品详细信息
The antibody detects endogenous levels of total GMFG protein.
靶标信息
Glia maturation factor gamma (GMFG) is a cytokine-responsive protein in erythropoietin-induced and granulocyte-colony stimulating factor-induced hematopoietic lineage development. It may be involved in glial differentiation, neural regeneration, and inhibition of tumor cell proliferation.
仅用于科研。不用于诊断过程。未经明确授权不得转售。